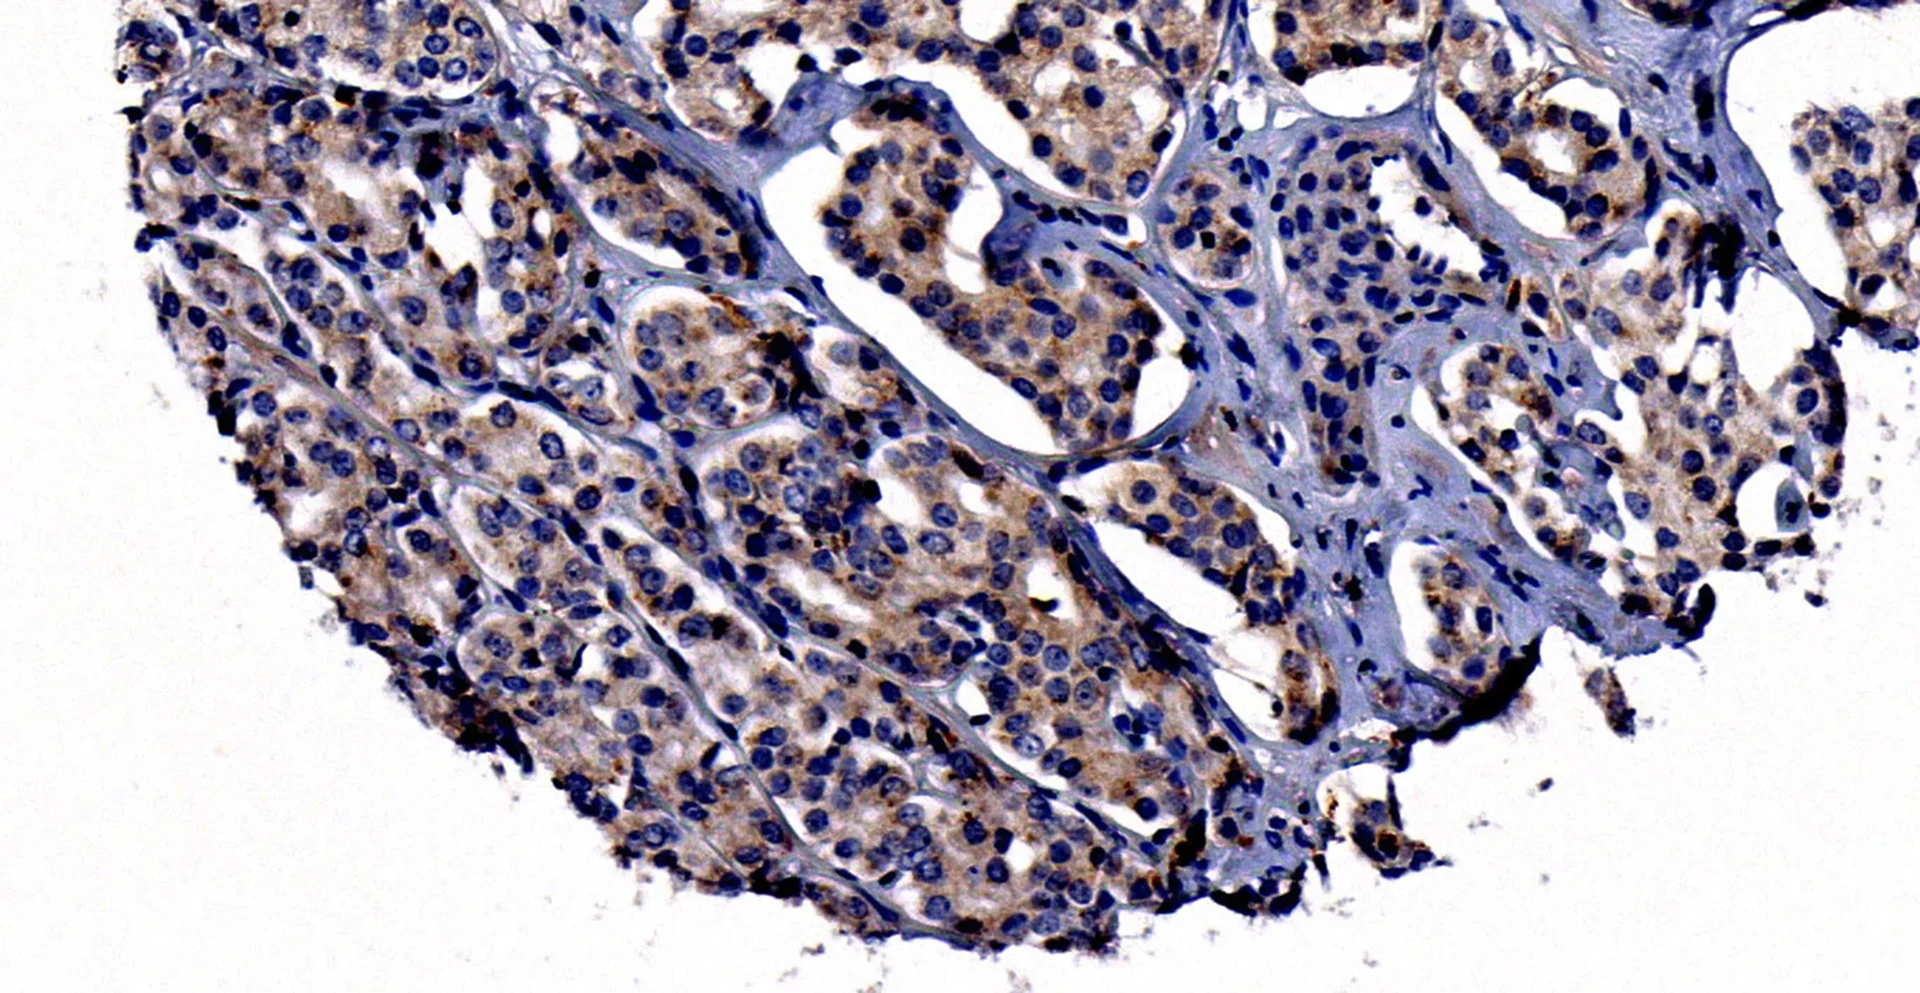
Prostatakarzinomzellen

Wenn Krebs die Vorsteherdrüse (Prostata) befällt, kann er auch in die Knochen streuen. In Deutschland sterben etwa drei von 100 Männern daran. Prostatakrebs stellt damit die dritthäufigste Krebserkrankung nach Lungen- und Darmtumoren dar. Im fortgeschrittenen Stadium können Knochenschmerzen und spontane Knochenbrüche auftreten.
“Wenn das Prostatakarzinom bereits in das Skelett gestreut hat, sind die Heilungschancen sehr schlecht”, sagt Dr. Michael Muders, der die Stiftungsprofessur für translationale Prostatakarzinomforschung der Rudolf-Becker-Stiftung im Institut für Pathologie des Universitätsklinikums Bonn (Direktor: Univ. Prof. Dr. Glen Kristiansen) innehat. Der Oberarzt sucht deshalb nach neuen Wegen, wie sich die Tumore hemmen lassen, um die Überlebenschancen der Patienten zu verbessern.
Zusammen mit Dr. Navatha Shree Polavaram und Prof. Dr. Kaustubh Datta vom University of Nebraska Medical Center (USA) sowie Wissenschaftlern der Mayo Clinic, Rochester (USA) und der Technischen Universität Dresden hat die Arbeitsgruppe um Prof. Muders die Rolle von Neuropilin 2 (NRP2) bei der Streuung der Prostatakarzinome untersucht. Dieses Protein befindet sich auf der Oberfläche von Krebs- und Knochenzellen (Osteoklasten). Letztere helfen bei der Regeneration des Skeletts mit, indem sie geschädigtes oder gealtertes Knochengewebe abbauen.
“Bei einer Vorstudie an der TU Dresden konnten wir zeigen, dass die Letalitätsraten der Patienten mit Prostatakarzinomen besonders hoch ist, wenn das Neuropilin 2 an den Zelloberflächen in größeren Mengen vorkommt”, berichtet Muders, der vor drei Jahren von der TU Dresden an das Universitätsklinikum Bonn kam.
Metastasen enthalten besonders viel Neuropilin 2
Zusammen mit seinen Kollegen aus der Pathologie der Mayo Clinic begutachtete Prof. Muders Gewebe, das sowohl aus dem Krebs in der Prostata als auch aus den Knochenmetastasen stammte. “Dabei zeigte sich, dass insbesondere die Metastasen viel Neuropilin 2 enthielten”, schildert Prof. Muders seine Forschungsergebnisse. „Daneben konnten wir zeigen, dass auch spezialisierte Knochenzellen, die sogenannten Osteoklasten, viel Neuropilin 2 aufweisen“, sagt Prof. Datta, zusammen mit Muders Korrespondenzautor der Studie. Daraus schlossen die Wissenschaftler, dass NRP2 bei der Absiedlung der Prostatakarzinome in das Skelett eine wichtige Rolle spielt.
Die Forscher prüften diese Hypothese an Mäusen, die ebenfalls an Prostatakarzinomen litten. Wurde das Gen für NRP2 in den Tieren in den Knochenzellen oder Krebszellen stumm geschaltet, kamen weniger Metastasen vor. “Wir konnten nachweisen, dass das NRP2 nicht nur in den Krebszellen, sondern auch in den abbauenden Knochenzellen eine wichtige Rolle spielt”, sagt Muders. Unter anderem scheint das Neuropilin 2 den Kalzium-Haushalt und gleichzeitig auch die Ausdifferenzierung der Knochenzellen zu beeinflussen.
Prof. Muders war mehrere Wochen an der Mayo Clinic in den USA, um dort zusammen mit dem Pathologen Raffael Jimenez Tumorgewebe von Prostatapatienten und die Signalkaskade zwischen Krebs- und Knochenzellen zu entschlüsseln.
“Wir sind dabei, Wirkstoffe zu suchen, die das Neuropilin 2 hemmen”, sagt Muders. Ein Ansatz sind sogenannte Nanopartikel, die zusammen mit Prof. Achim Aigner von der Universität Leipzig entwickelt werden. Auch prüfen die Wissenschaftler in enger transatlantischer Kooperation, ob es bereits Medikamente auf dem Markt gibt, die das Neuropilin blockieren können.
Finanzierung und beteiligte Institutionen:
An der Studie sind das University of Nebraska Medical Center, Omaha (USA), das Universitätsklinikum und die TU Dresden, die Mayo Clinic, Rochester (USA), die School of Medicine, Salt Lake City (USA), und die Universität Bonn beteiligt. Gefördert wurde die Arbeit unter anderem durch die Deutsche Forschungsgemeinschaft, die Rudolf-Becker-Stiftung und die Medizinische Fakultät der Universität Bonn (BonFor).
Publikation: Navatha Shree Polavaram, Samikshan Dutta, Ridwan Islam, Arup K. Bag, Sohini Roy, David Poitz, Jeffrey Karnes, Lorenz C. Hofbauer, Manish Kohli, Brian A. Costello, Raffael Jimenez, Surinder K. Batra, Benjamin A. Teply, Michael H. Muders, Kaustubh Datta: Tumor- and osteoclast-derived NRP2 in prostate cancer bone metastases. Bone Research, DOI: 10.1038/s41413-021-00136-2
Link zur Publikation: https://www.nature.com/articles/s41413-021-00136-2